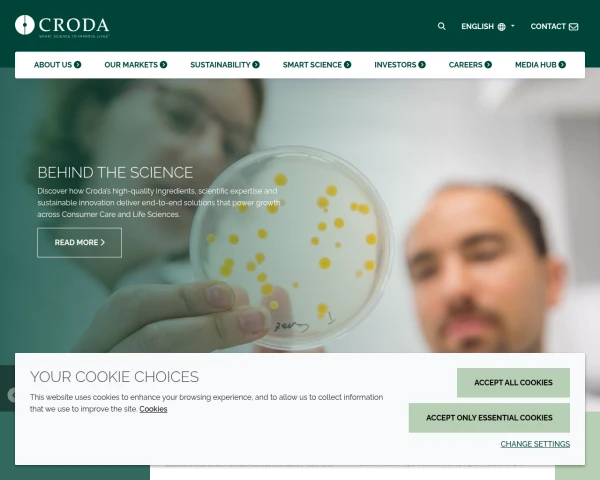

This report is based on an automated assessment of 25 webpages on 6th March 2026.
78
%GoodAccessibility
- 38th place in FTSE 350
WCAG Levels
These measure compliance against the WCAG 2.2 standard. What does this mean?
- Level A - 82.1%
- Level AA - 73.9%
- Level AAA - 66.8%
These measure compliance against the WCAG 2.2 standard. What does this mean?
Recommendations
| Priority | Recommendation | Progress |
|---|---|---|
WCAG 2.2 AAA 2.4.13 | 0% | |
WCAG 2.2 AA 2.4.11 | 0% | |
WCAG 2.0 A 1.3.1 | 58.3% | |
WCAG 2.2 AAA 2.4.12 | 0% | |
WCAG 2.0 AA 2.4.7 | 96.4% |
Fix any of these to unlock more recommendations
This scan is based on just a sample of your website. How we sample pages